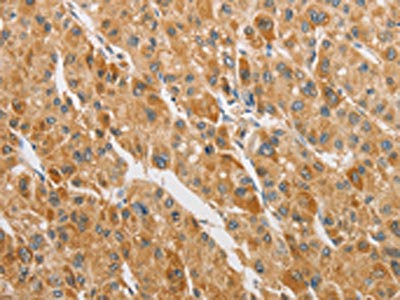

ARHGAP5 Antibody
-
中文名稱:ARHGAP5兔多克隆抗體
-
貨號:CSB-PA564021
-
規(guī)格:¥1100
-
圖片:
-
The image on the left is immunohistochemistry of paraffin-embedded Human colon cancer tissue using CSB-PA564021(ARHGAP5 Antibody) at dilution 1/30, on the right is treated with fusion protein. (Original magnification: ×200)
-
The image on the left is immunohistochemistry of paraffin-embedded Human liver cancer tissue using CSB-PA564021(ARHGAP5 Antibody) at dilution 1/30, on the right is treated with fusion protein. (Original magnification: ×200)
-
-
其他:
產(chǎn)品詳情
-
Uniprot No.:
-
基因名:
-
別名:Arhgap5 antibody; p190-B antibody; RHG05_HUMAN antibody; Rho GTPase activating protein 5 antibody; Rho GTPase-activating protein 5 antibody; Rho-type GTPase-activating protein 5 antibody
-
宿主:Rabbit
-
反應(yīng)種屬:Human,Mouse
-
免疫原:Fusion protein of Human ARHGAP5
-
免疫原種屬:Homo sapiens (Human)
-
標(biāo)記方式:Non-conjugated
-
抗體亞型:IgG
-
純化方式:Antigen affinity purification
-
濃度:It differs from different batches. Please contact us to confirm it.
-
保存緩沖液:-20°C, pH7.4 PBS, 0.05% NaN3, 40% Glycerol
-
產(chǎn)品提供形式:Liquid
-
應(yīng)用范圍:ELISA,IHC
-
推薦稀釋比:
Application Recommended Dilution ELISA 1:1000-1:5000 IHC 1:50-1:200 -
Protocols:
-
儲存條件:Upon receipt, store at -20°C or -80°C. Avoid repeated freeze.
-
貨期:Basically, we can dispatch the products out in 1-3 working days after receiving your orders. Delivery time maybe differs from different purchasing way or location, please kindly consult your local distributors for specific delivery time.
-
用途:For Research Use Only. Not for use in diagnostic or therapeutic procedures.
相關(guān)產(chǎn)品
靶點(diǎn)詳情
-
功能:GTPase-activating protein for Rho family members.
-
基因功能參考文獻(xiàn):
- only collagen-IV elicits the formation of proteolytically active podosomes through a mechanism involving increased Src phosphorylation, p190RhoGAP-B (also known as ARHGAP5) relocalisation and MT1-MMP (also known as MMP14) cell surface exposure at podosome sites. PMID: 27231093
- Brazilian Amerindian ancestry compared to Asian, European, and African Genomes.SNPs within or proximal to CIITA (rs6498115), SMC6 (rs1834619), and KLHL29 (rs2288697) were most differentiated in the Amerindian-specific branch. SNPs in ADAMTS9 (rs7631391), DOCK2 (rs77594147), SLC28A1 (rs28649017), ARHGAP5 (rs7151991), and CIITA (rs45601437) in the Asian comparison. PMID: 28100790
- This newly identified miR-744/ARHGAP5 pathway provides further insight into the progression and metastasis of NPC and indicates potential novel therapeutic targets for NPC. PMID: 25961434
- Ectopic expression of p190B suppressed the miR-494-induced EGFR upregulation. PMID: 24316134
- The expression level of miR-486-5p was inversely correlated with that of ARHGAP5. PMID: 23474761
- RhoA is down-regulated at cell-cell contacts via p190RhoGAP-B in response to tensional homeostasis. PMID: 23552690
- Data indicate a role for p120-catenin (amino acids 820-843) domain in the p120-catenin.p190RhoGAP signaling complex assembly and membrane targeting. PMID: 23653363
- A cell cycle-regulated reduction in endogenous p190 levels is linked to completion of cytokinesis and generation of viable cell progeny. PMID: 14610059
- precise control of p190-B Rho GTPase-activating protein activity is critical for normal branching morphogenesis during mammary gland development PMID: 16469769
- Results link Cdk5 to Rho-ROCK signaling via Src and p190RhoGAP and implicate Cdk5 in the regulation of cell contraction, attachment, and migration. PMID: 19822667
顯示更多
收起更多
-
亞細(xì)胞定位:Cytoplasm. Cell membrane; Peripheral membrane protein.
-
組織特異性:Detected in skin fibroblasts (at protein level).
-
數(shù)據(jù)庫鏈接:
Most popular with customers
-
YWHAB Recombinant Monoclonal Antibody
Applications: ELISA, WB, IHC, IF, FC
Species Reactivity: Human, Mouse, Rat
-
Phospho-YAP1 (S127) Recombinant Monoclonal Antibody
Applications: ELISA, WB, IHC
Species Reactivity: Human
-
-
-
-
-
-